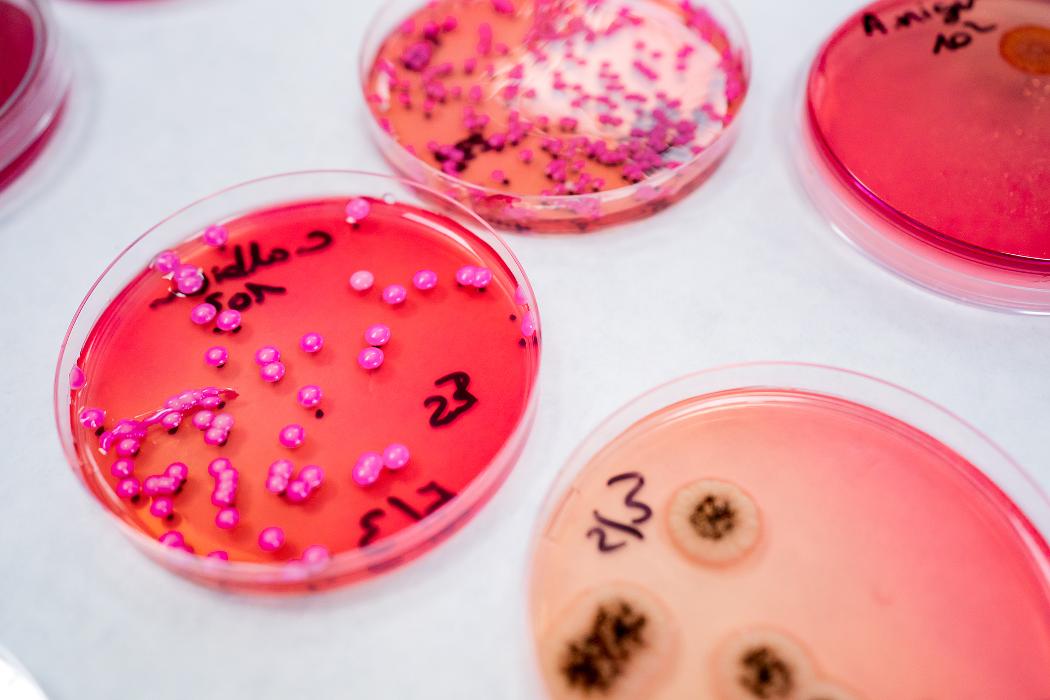

Business claimed
Last updated: 4 months ago
Listed in:
Tutoring
,
Mental and Addiction Care Facilities
About Neejad LLC
Neejad LLC, based in Dublin OH, is dedicated to empowering excellence in medical education and health. We offer innovative, evidence-based online courses and resources tailored to healthcare professio Go to full description...
Contact information
Phone numbers
Business hours
Today: 12:00AM - 12:00AM
▼
Business website
Additional business details
Email address:
neejad@neejad.com
Payment methods accepted:
PAYPAL, APPLEPAY
Neejad LLC, based in Dublin OH, is dedicated to empowering excellence in medical education and health. We offer innovative, evidence-based online courses and resources tailored to healthcare professionals and patients. Our commitment to quality and advancement sets us apart, driving progress and ensuring up-to-date medical knowledge. Discover a trusted source for continuing medical education and health literacy right here in Zipcode 43016, with a unique focus on excellence, accessibility, and impact.
Services:
educational services, professional healthcare services
Languages:
English
Brands:
NEEJAD